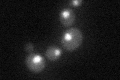
YPR025C
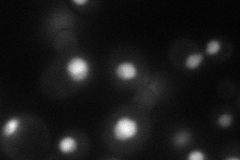
YPR025C
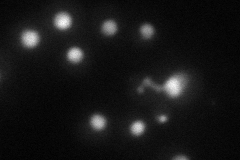
YPR025C
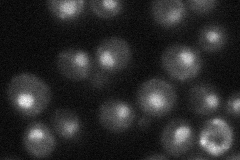
YPR025C
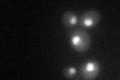
YPR025C

View description
Cyclin associated with protein kinase Kin28p, which is the TFIIH-associated carboxy-terminal domain (CTD) kinase involved in transcription initiation at RNA polymerase II promoters
Localization:
Intensity:
Fold change:
Significance:
-
C’ GFP library in SD
nucleus30.57 -
N' NOP1pr-GFP in SD
nucleus58.0738 -
N' TEF2pr-mCherry in SD
nucleus33.4016 -
N' NATIVEpr-GFP in SD
nucleus28.1307 -
N' TEF2pr-VC and Cyto-VN in SD

#N/A0 -
C’ GFP library in SD+DTT
nucleus26.510.86No -
C’ GFP library in SD+H2O2

nucleus27.860.91No -
C’ GFP library in Starvation Media

nucleus36.191.18No -
C’ GFP library on the background of Pup2-DaMP

nucleus -
C’ GFP library on the background of CCT mutant

nucleus28.53950.933317No
